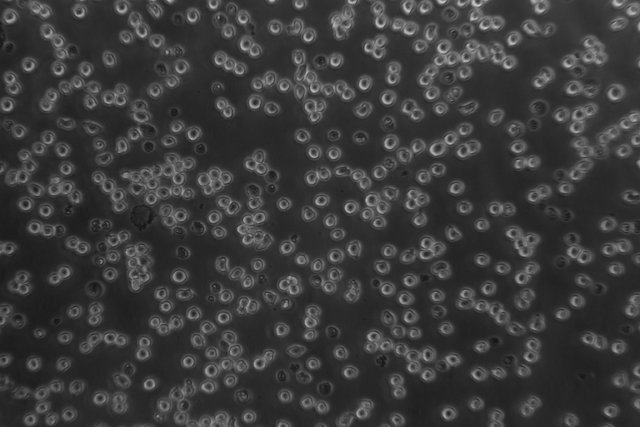
产品细节图片8

相关产品推荐更多 >
万千商家帮你免费找货
0 人在求购买到急需产品
- 详细信息
- 询价记录
- 文献和实验
- 技术资料
- 库存:
10
- 供应商:
广州科适特科学仪器有限公司
- 现货状态:
货期15天
- 保修期:
1年
- 规格:
KOSTER IMC 800T

平视场大视野目镜:WF10X, 视场:22mm
目镜接口: 30mm
齐焦距离:10mm
9W LED,亮度可调
明场物镜: 10X, 20X, 40X
相差物镜:10X
转换器:五孔转换器
聚光镜:长工作距离聚光镜,工作距离70mm,带插板式相衬装置;
载物台:移动范围(横向X纵向):112mmX79mm, 移动尺可拆卸;
培养皿托板:多孔板样品夹,通用样品夹;
相衬系统:拉板式相衬聚光镜,相衬环中心可调;
参考用户名单: 暨南大学 生科院,第二理工楼 8楼, 李丽娟老师
中山大学附属眼科医院, 黄丽萍 老师
珠江水产研究所,吴建发老师
华南新药创制中心,张老师
华南师范大学 生命科学学院 乔志新教授
深圳大学医学院 吴兵雄老师
中山大学第三附属医院 科技楼7楼,分子免疫实验室
| 技术规格 | |||||||||
| 主要参数 | 总放大倍数 | 40X~400X(标准配置) | |||||||
| 机械筒长 | ∝ | ||||||||
| 物镜共轭距离 | ∝ | ||||||||
| 目 镜 | 平视场大视野目镜 | WF 10X | 视场:Ф22mm | 目镜接口 Ф30mm |
齐焦距离 10mm |
||||
| 对中望远镜 | |||||||||
| 目镜筒 | 45°倾斜,双目瞳距调节范围:48~75mm,眼点高度从台面起高为400mm。 | ||||||||
| 明场物镜 | 放大倍率 | 数值孔径 | 工作距离(mm) | 盖玻片厚度(mm) | 备注 | ||||
| 10X | 0.25 | 4.27 | 1.2 | ||||||
| 20X | 0.40 | 8.0 | 1.2 | ||||||
| 40X | 0.60 | 3.5 | 1.2 | ||||||
| 相衬物镜 | 10X | 0.25 | 4.27 | 1.2 | 标“PHP2” | ||||
| 转换器 | 五孔转换器 | ||||||||
| 调焦机构 | 粗微动同轴, 微动格值:2μ, 粗动松紧可调,带锁紧和限位装置,有效调焦行程11mm | ||||||||
| 聚光镜 | 长工作距离聚光镜,工作距离70mm,带插板式相衬装置 |
||||||||
| 载物台 | 移动范围(横向X纵向):112mmX79mm, 移动尺可拆卸 | ||||||||
| 培养皿托板 | 86mm(宽)X129.5mm(长),可适配圆形培养皿Ф87.5mm | ||||||||
| 34mm(宽)X77.5mm(长),可适配圆形培养皿Ф68.5mm | |||||||||
| 57mm(宽)X82mm(长) | |||||||||
| 相衬系统 |
相位相衬 | 拉板式相衬聚光镜,相衬环中心可调 | |||||||
| 照明系统 | 9W LED,亮度可调 | ||||||||
| 滤色片 | 磨砂玻璃,蓝滤色片 | ||||||||
| 调校工具 | 内六角扳手(M4、M5) | ||||||||

风险提示:丁香通仅作为第三方平台,为商家信息发布提供平台空间。用户咨询产品时请注意保护个人信息及财产安全,合理判断,谨慎选购商品,商家和用户对交易行为负责。对于医疗器械类产品,请先查证核实企业经营资质和医疗器械产品注册证情况。
- 作者
- 内容
- 询问日期
 文献和实验
文献和实验分析、光密度统计以及细胞形态的测量。 (四)、暗视野显微镜 暗视野显微镜(dark field microscope,图2-7)的聚光镜中央有当光片,使照明光线不直接进人物镜,只允许被标本反射和衍射的光线进入物镜,因而视野的背景是黑的,物体的边缘是亮的。利用这种显微镜能见到小至 4~200nm的微粒子,分辨率可比普通显微镜高50倍。 图2-7 暗视野照明方式 (五)、相差显微镜 相差显微镜(phasecontrast microscope,图2-8、9)由P.Zernike于1932年发明
一、 常规操作 1. 穿着专用实验服。自己的白大衣或厚外套,可脱在门外的衣帽架上。 2. 穿着专用拖鞋。在缓冲间换下自己的鞋子,尽量避免在缓冲间走动、停留。 3. 细胞房最多可4个人同时使用。尽量避免在内长时间逗留、交谈。二、 培养箱使用规则 1. 从培养箱取放物品前,用酒精清洁双手(或手套),尽量缩短开门时间和减少开门次数。 注: 培养箱中的空气是经过过滤的洁净空气。长时间敞开或频繁开关培养箱,容易造成污染。 2. 培养瓶皿放入培养箱前,用酒精
转眼间这学期已经快过去一半了,该是时候进入实验室学习实验技能,初来乍到的你会不会因为「笨手笨脚」被师兄师姐嫌弃呢。不要担心,本文为各位细胞小白带来细胞实验步骤和细节讲解,希望你看过之后能对细胞实验有个清晰的了解,只要你足够的细心,看完之后完全有能力自己独立操作哦……基本准备工作灭菌、消毒1. 无菌室和操作区消毒实验前用 70% 乙醇擦净洁净台,再将实验器材放入超净工作台,打开紫外线灭菌灯,40 分钟后消毒完毕,关闭紫外线灯,打开吹风,注意两扇门不要同时打开。细胞房每周都要打开房间的紫外线灭菌











